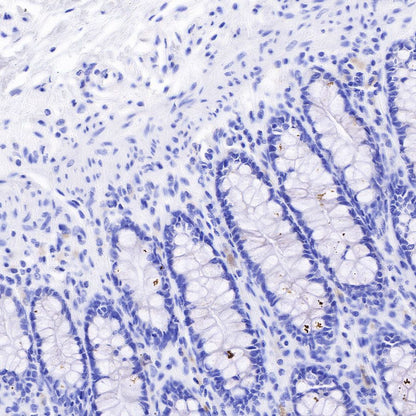

IHC shows positive staining in paraffin-embedded human lung cancer. Anti-Claudin18.2 + Claudin18.1 antibody was used at 1/1000 dilution, followed by a HRP Polymer for Mouse & Rabbit IgG (ready to use). Counterstained with hematoxylin. Heat mediated antigen retrieval with Tris/EDTA buffer pH9.0 was performed before commencing with IHC staining protocol.
Product Details
Product Details
Product Specification
| Host | Rabbit |
| Antigen | CLAUDIN18.2 + CLAUDIN18.1 |
| Synonyms | N/A |
| Immunogen | Synthetic Peptide |
| Location | Cytoplasm, Cell membrane |
| Accession | P56856 |
| Clone Number | SDT-298-29 |
| Antibody Type | Recombinant mAb |
| Application | IHC-P, ICC |
| Reactivity | Hu |
| Purification | Protein A |
| Concentration | 0.5 mg/ml |
| Tag | N/A |
| Physical Appearance | Liquid |
| Storage Buffer | PBS, 40% Glycerol, 0.05% BSA, 0.03% Proclin 300 |
| Stability & Storage | 12 months from date of receipt / reconstitution, -20 °C as supplied |
Dilution
| application | dilution | species |
| IHC-P | 1:1000 | |
| ICC | 1:500 |
Background
Claudin 18 is a protein that in humans is encoded by the CLDN18 gene. It belongs to the group of claudins. CLDN18 belongs to the large claudin family of proteins, which form tight junction strands in epithelial cells. The claudin-18 gene has two splice variants: claudin 18.1, which is found primarily in the lung, and claudin 18.2, which is expressed exclusively in the stomach.
Picture
Picture
Western Blot

Immunohistochemistry

IHC shows positive staining in paraffin-embedded human lung. Anti-Claudin18.2 + Claudin18.1 antibody was used at 1/1000 dilution, followed by a HRP Polymer for Mouse & Rabbit IgG (ready to use). Counterstained with hematoxylin. Heat mediated antigen retrieval with Tris/EDTA buffer pH9.0 was performed before commencing with IHC staining protocol.

IHC shows positive staining in paraffin-embedded human stomach. Anti-Claudin18.2 + Claudin18.1 antibody was used at 1/1000 dilution, followed by a HRP Polymer for Mouse & Rabbit IgG (ready to use). Counterstained with hematoxylin. Heat mediated antigen retrieval with Tris/EDTA buffer pH9.0 was performed before commencing with IHC staining protocol.

IHC shows positive staining in paraffin-embedded human colon cancer. Anti-Claudin18.2 + Claudin18.1 antibody was used at 1/1000 dilution, followed by a HRP Polymer for Mouse & Rabbit IgG (ready to use). Counterstained with hematoxylin. Heat mediated antigen retrieval with Tris/EDTA buffer pH9.0 was performed before commencing with IHC staining protocol

Negative control: IHC shows negative staining in paraffin-embedded human colon. Anti-Claudin18.2 + Claudin18.1 antibody was used at 1/1000 dilution, followed by a HRP Polymer for Mouse & Rabbit IgG (ready to use). Counterstained with hematoxylin. Heat mediated antigen retrieval with Tris/EDTA buffer pH9.0 was performed before commencing with IHC staining protocol.

Negative control: IHC shows negative staining in paraffin-embedded human cervical squamous cell carcinoma. Anti-Claudin18.2 + Claudin18.1 antibody was used at 1/1000 dilution, followed by a HRP Polymer for Mouse & Rabbit IgG (ready to use). Counterstained with hematoxylin. Heat mediated antigen retrieval with Tris/EDTA buffer pH9.0 was performed before commencing with IHC staining protocol.
Immunocytochemistry

ICC shows positive staining in KATOIII cells. Anti-Claudin18.2 + Claudin18.1 antibody was used at 1/500 dilution (Green) and incubated overnight at 4°C. Goat polyclonal Antibody to Rabbit IgG - H&L (Alexa Fluor® 488) was used as secondary antibody at 1/1000 dilution. The cells were fixed with 4%PFA and permeabilized with 0.1% PBS-Triton X-100. Nuclei were counterstained with DAPI (Blue).